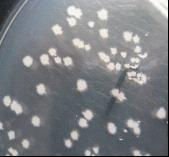
Feed Grade Bacillus Natto

Supplier Types:
Products Types :
Filter Results :
Min Order :
Price :
Payment Type :
Business Type :
Supplier Types :
Gold SupplierSGS Certification
Platform Certification
Products Types :
Product sample
Pay online
Filter Results :
The Belt And Road
Online Expo
Video
Min Order :
Price :
Payment Type :
- L/C
- T/T
- D/P
- Paypal
- Money Gram
- Western Union
- Other
Business Type :
- Agent
- Distributor/Wholesaler
- Manufacturer
- Organization
- Retailer
- Service
- Trade Company
- Other
Cancel
Submit
$30.00
Min-Order : 1 Kilogram
Contact Now
$0.13
Min-Order : 1 piece
Contact Now
- 1
- 2
- 3
- 4
- 42